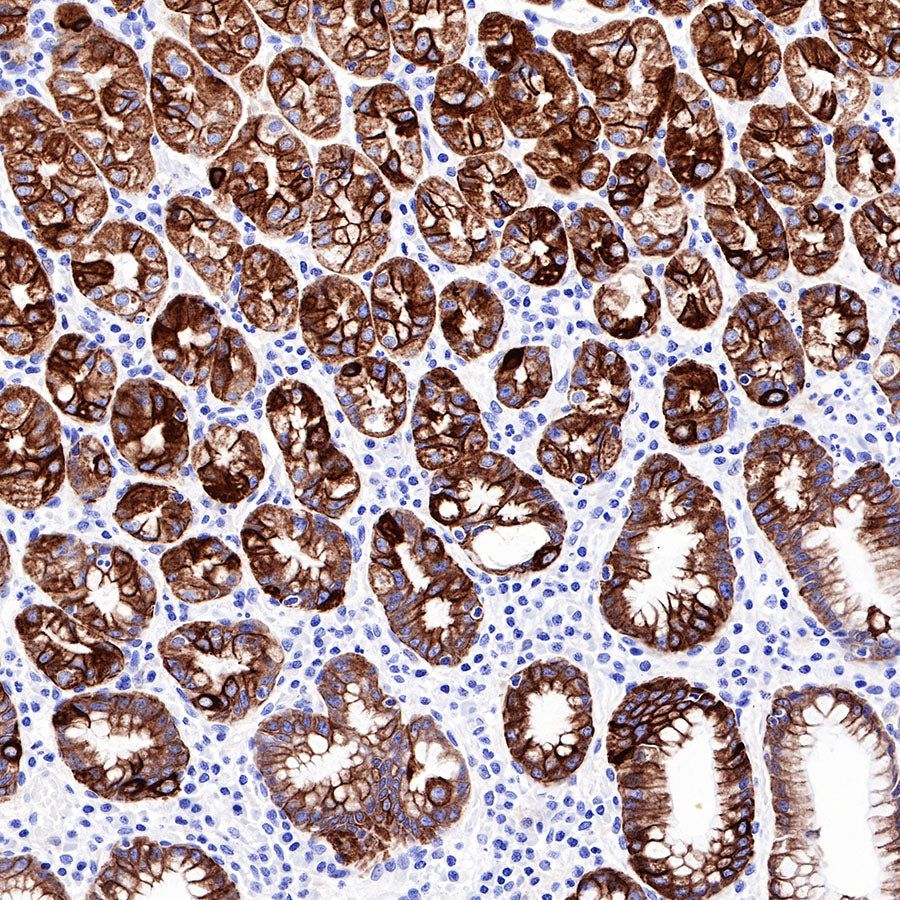
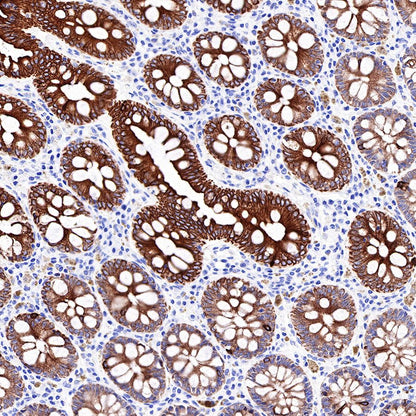
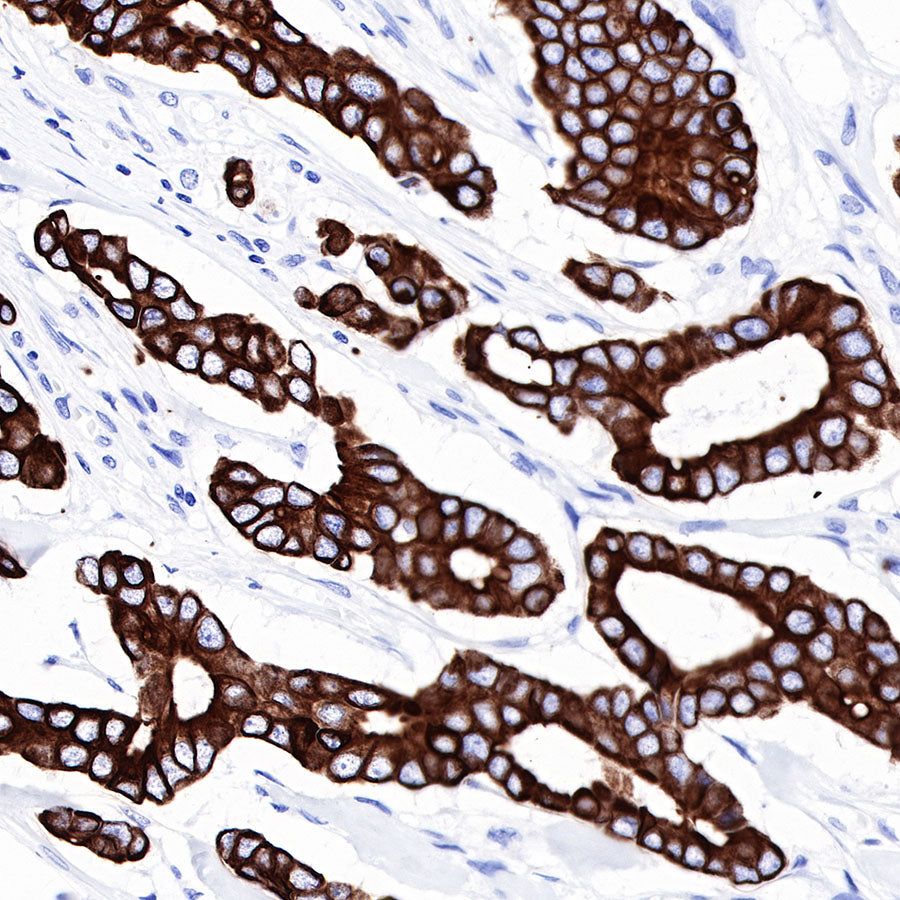
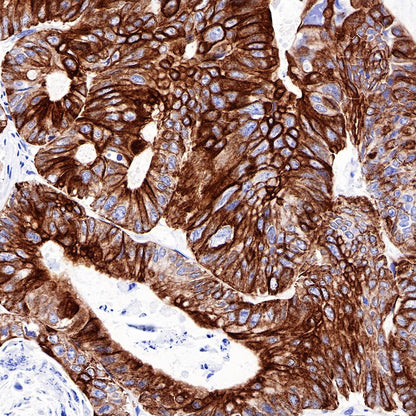
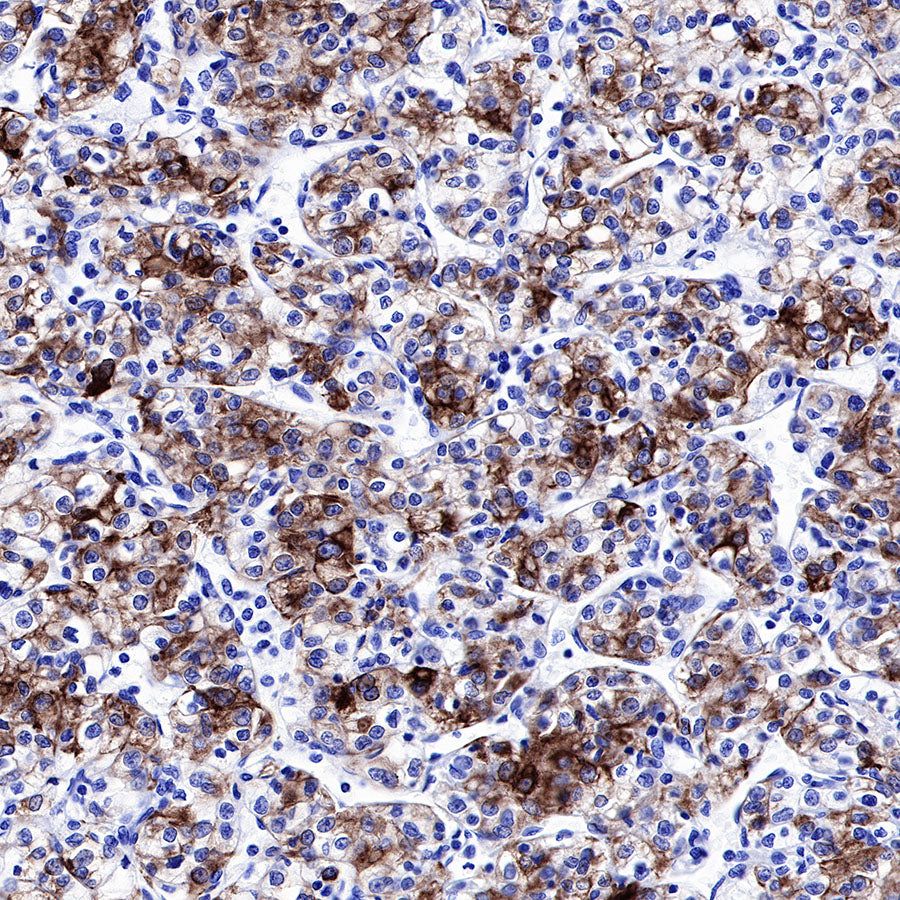
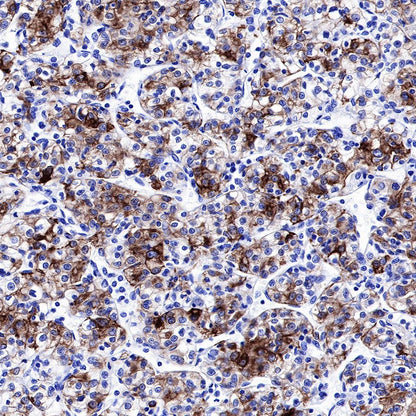

Product Specification
| Host |
Rabbit |
| Antigen |
CK-LMW |
| Synonyms |
Cytokeratin (LMW), LMW-CK |
| Immunogen |
N/A |
| Location |
Cytoplasm |
| Clone Number |
SDT-P003 |
| Antibody Type |
Rabbit mAb |
| Application |
WB, IHC-P, IF |
| Reactivity |
Hu |
| Purification |
Protein A |
| Concentration |
Lot specific* (generally 0.35 to 0.55 mg/ml)* |
| Physical Appearance |
Liquid |
| Storage Buffer |
PBS, 40% Glycerol, 0.05% BSA, 0.03% Proclin 300 |
| Stability & Storage |
12 months from date of receipt / reconstitution, -20 °C as supplied |
Dilution
| application |
dilution |
species |
| WB |
1:1000 |
|
| IHC-P |
1:500-1:2000 |
|
| IF |
1:500 |
|
Background
CK-LMW is low molecular weight cytokeratins and is expressed in monolayer or glandular epithelium of normal or tumor tissues, such as thyroid, breast, gastrointestinal or respiratory epithelium. It is expressed in adenocarcinoma and the vast majority of nonkeratinizing squamous cell carcinoma, but not in keratinizing squamous cell carcinoma. It combined with CK5/6 for diagnosis of adenocarcinoma and squamous carcinoma.